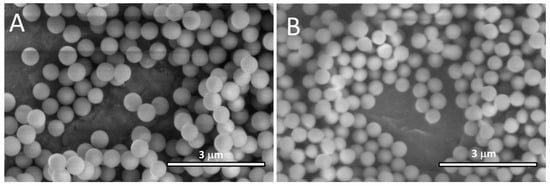

Abstract
Several traditional methods for producing polymer microparticle adsorbents for metal ions exist, such as bulk polymerization followed by milling and crushing the material to micron-size particles, precipitation from organic solvents, and suspension polymerization utilizing surfactants. Alternative methods that are easily scalable and are environmentally friendly are in high demand. This study employs Pickering Emulsion Polymerization Technology (PEmPTech) to synthesize nanostructured polymer microspheres that incorporate Schiff-base ligands, which can be utilized for metal ion adsorption, and specifically Cu(II) ions. Our innovative approach makes use of nanoparticle-stabilized, surfactant-free emulsions/suspensions, enabling the straightforward production of ligand-bearing microspheres while allowing for the precise modulation of the polymer matrix chemistry to maximize adsorption capacities. Through this method, we demonstrate notable enhancements in Cu(II) ion adsorption, which correlates with both the polarity of the monomers used and the concentration of Schiff-base ligands within the microspheres. Notably, our results offer insights into the structure–activity relationships essential for designing tailored adsorbents. This work provides a scalable method to produce high-performance adsorbents and also contributes to sustainable methodologies by excluding harmful surfactants and solvents.
1. Introduction
The contamination of water bodies with toxic metal ions is a critical environmental challenge that has significant health implications [1,2]. The non-specific interactions of these metal ions with biological functionalities can disrupt essential biological processes, leading to severe health disorders [3,4,5]. Given this backdrop, there is an urgent need for efficient and selective adsorption materials that can address these concerns sustainably [6]. Several existing technologies for the production of adsorbents in the form of polymer powders [7,8,9] or polymer monoliths [10,11,12] and even cheap materials from agricultural waste, food waste, biomass, inorganic materials, and natural polymers have been considered and explored [13,14,15]. Among these materials, polymer adsorbents are especially attractive, offering a platform for rational design at the molecular level, tuning the structure–activity relationship as well as selectivity by imprinting with a variety of ligands. The emerging Pickering Emulsion Polymerization Technology (PEmPTech) represents a promising approach to the facile synthesis of such materials due to its green, water-based process, avoiding the use of solvents and surfactants that are difficult to remove and are harmful to the environment [16,17,18]. Traditional methods for producing micron-size polymer particle adsorbents are bulk polymerization and crushing to micron size with mechanical methods, precipitation from organic solvents, suspension polymerization, two-step swelling, core–shell, etc. [19,20]. PEmPTech resembles suspension polymerization technology for producing polymer microspheres. However, in the case of suspensions, the dispersion is stabilized by a surfactant polymer or a pseudo-surfactant such as polyethylene glycol (PEG), polyvinyl alcohol (PVA) [20], or even hydroxypropyl methyl cellulose [21], and in the case of Pickering emulsions, the stabilizers are amphiphilic nanoparticles. Another traditional method for producing polymer microspheres is the precipitation method [11,22], which makes use of organic solvents in which the monomers are initially dissolved; however, this method is least preferred due to environmental concerns related to the use of volatile organic solvents. This study builds on the existing PEmPTech framework [23] that uses a green water solvent for the synthesis of microparticles and environmentally neutral silica nanoparticles [24] instead of surfactants as emulsion stabilizers to generate efficient metal ion adsorbents by incorporating ligands into the polymer microspheres. Among various ligands, Schiff bases are known for their effective metal chelating properties [25]. Another great advantage of manufacturing polymer adsorbents for metal ions is the ability to reversibly bind and release metal ions; for example, a Schiff base is typically active for binding at neutral pH, the typical pH of most environmental water bodies, and it can release metal ions at acidic pH values due to the protonation of the amine centers. Several studies have focused on the generation of metal ion adsorption based on incorporating Schiff-base ligands into a polymer matrix or surface immobilization onto microparticles [26,27,28,29]. However, the main challenge in incorporating the Schiff-base ligands or even Schiff-base ligand complexes into polymer microspheres to generate true ion-imprinted metal ion adsorbents in the form of microspheres is the different polymerization kinetics between a vinyl-bearing Schiff-base ligand or Schiff-base metal ion complex and the monomer of the polymer matrix. Mechanistically, such a reaction should be carried out using suspension polymerization to preserve the locus of the polymerization inside the oil droplet. In addition, the suspension has to be sufficiently stable at higher temperatures or during UV exposure during polymerization. To date, there are very few reports of Schiff-base ion-imprinted polymer microspheres derived from suspension polymerization [30,31], whereas most Schiff-base ion-imprinted polymers are obtained via bulk polymerization [32]. Previous iterations of PEmPTech reported by our group utilized only vinyl pyridine ligands, while the current approach focuses on tuning the interactions between the Schiff-base ligands and the polymer matrix to enhance the material’s overall performance. This adjustment aims to create a system that not only efficiently adsorbs metal ions but also aligns with environmental sustainability by minimizing the ecological footprint of the adsorption process.
2. Materials and Methods
2.1. Materials
Tetraethylorthosilicate (TEOS) 99%, (3-glycidoxypropyl)trimethoxysilane (GLYMO), trimethoxy(octyl)silane 97% (OTS), benzyl metacrylate (BM) 96% containing monomethyl ether hydroquinone as inhibitor, ethylene glycol dimethacrylate (EGDMA) 98% stabilized with hydroquinone monomethyl ether, vinylacetate (VAc) 99% containing 3–20 ppm hydroquinone as inhibitor, 1,1′-azobis(cyclohexanecarbonitrile) (ACHN) 98%, 2-(Dimethylamino)ethyl methacrylate (DAEMA) containing 700–1000 ppm monomethyl ether hydroquinone as inhibitor 98%, allylamine 98%, salicylaldehide 98%, sodium 4-vinylbenzenesulfonate technical 90% (NaVBS), dimethyl sulfoxide (DMSO), aluminium oxide (active basic) Brockmann I, N,N-Dimethylformamide anhydrous 99.8% and ammonium hydroxide solution (28–30%) EMSURE ACS. Reag. Ph Eur. Supelco were purchased from Sigma-Aldrich ((Merck, KGaA, Darmstadt, Germany); ethanol absolute (EtOH, 99.3%), hydrochloric acid (HCl), Cu(CH3COO)2·H2O, and Co(CH3COO)2·4H2O were purchased from Chemical Company (Iasi, Romania).
2.2. Synthesis of Silica Nanoparticles
The preparation procedure for silica nanoparticles (NPs) and silica nanoparticles functionalized with epoxy by reaction with GLYMO (NP-Gly) and alkyl chain (NP-C8) has been reported [33,34]. Briefly, the synthesis of silica nanoparticles proceeded as follows: In a 1000 mL round-bottom flask, 9 mL TEOS, 300 mL EtOH, 33 mL H2O, and 27.7 mL NH4OH were added. The reaction mixture was stirred at room temperature at 1000 rpm. A second mixture of 54 mL TEOS and 200 mL EtOH was added drop-wise via separatory funnel for about 3 h. The reaction mixture was left for 24 h at room temperature. At the end, the reaction mixture was neutralized with 18 mL of HCl. After reaction, the NPs were separated by centrifugation and washed three times with EtOH and three times with water. For the surface modification of NPs, 6.0 g of silica nanoparticles (40 mL of EtOH) was added to a 250 mL flask. Then, 100 mL EtOH was added, and the mixture was kept under Argon atmosphere. The reaction mixture was continually stirred at 1000 rpm. Then, 10–12 mL of GLYMO or OTS was added drop by drop to the reaction mixture. The reaction mixture was heated and maintained at 60 °C for 24 h. The functionalized NPs were washed three times with EtOH and another three times with water, and were finally re-dispersed in water. The SEM images of the obtained nanoparticles are given in Figure 1.
Figure 1.
SEM images of the silica nanoparticles at two different magnifications for (A) NP-Gly 520 ± 10 nm and (B) NP-C8 470 ± 10 nm.
2.3. Synthesis of Schiff-Base Ligand: 2-((Allylimino)methyl)phenol and Complex with Copper (II)
For the synthesis of the Schiff-base ligand, we have used a modified method from the one reported in the literature [35]. Allylamine (20 mmol) was dissolved in 40 mL of absolute ethanol and added slowly to a stirred solution of salicylaldehyde (20 mmol) dissolved in 40 mL absolute ethanol. The mixture was then stirred for 24 h at 25 °C for removal of solvent under vacuum in a rotary evaporator. The result was an orange-yellow oil.
Copper (II) complex: A solution of 2-((allylimino)methyl)phenol (2 mmol) in absolute ethanol to which was added a solution of CuCl2 (1 mmol). Immediately, dark green-brown crystals precipitated out of the solution. The reaction time was 24 h and the precipitate was collected by filtration and later washed with hexane.
2.4. Polymer Microsphere Synthesis via Pickering Emulsion Polymerization
Water-immiscible vinyl-bearing monomers BM, VAc, and DAEMA, having different polarities, whose chemical structures are given in Figure 2B, and a crosslinking monomer EGDMA, were used for the Pickering emulsion preparation and polymerization. Pickering emulsion was produced by first adding 30 mg of ACHN radical initiator to a 20 mL glass scintillator vial, followed by 1 mL of monomer and 1 mL of EGDMA crosslinker, the complex was dissolved in DMSO, and after 5 min the mixture become homogeneous. Next, 5 mg of colloidal particles and 12 mL of water were added. The glass scintillator vial was then vortexed for 1 min at 2000 rpm. The Pickering emulsions were next polymerized in an oil bath for 4 h at 90 °C. After the polymerization, the product was filtered and thoroughly washed with approximately 25 mL of ethanol to remove the unreacted monomer, and subsequently dried at room temperature.

Figure 2.
(A) Schematics showing the synthesis reaction for the Schiff-base complex; (B) chemical structure of the monomers for generating the polymer microspheres; (C) the polymerization reaction of the Pickering emulsion droplets and formation of polymer microspheres with sites for metal ion adsorbents.
2.5. Characterization of the Materials
Scanning electron microscopy: nanoparticles were characterized with a Verios G4 UC (Thermo Fischer Scientific Inc., Eindhoven, The Netherlands) scanning electron microscope (SEM) with a 5 keV beam energy, using an Everhart–Thornley detector, beam spot 50 pA.
Optical microscopy: the polymer microsphere adsorbent were analyzed with an IM-5FLD inverted fluorescence microscope (Optika Srl, Ponteranica, Italy) equipped with an 8 W XLED illumination source for sample analysis under transmitted light; 5 W LED excitation illumination sources at 470, 560, and 385 nm, and UV, blue, and green filter sets for sample analysis in fluorescence mode; a color digital Camera Optica C-P6, 6.3 MP; and Optika ProView (Optika Srl, Ponteranica, Italy) software (version number 4.11.20805) for image capturing and processing.
2.6. Measurement of Ion Extraction and Recovery Capacity of Polymer Absorbents
The concentration of metal ions in the diluted supernatant and filtrate was determined using a UV-vis spectrophotometer (DLAB Scientific Co., LTD., Beijing, China,) after the calibration curves were generated for the maximum absorption wavelength λmax = 810 nm for CuCl2.
For the ion recovery, which refers to the recovery of metal ions from the polymer adsorbent, a weighted amount polymer adsorbent, typically 1 g, was mixed into 15 mL 5% HCl solution. The samples were then left in this condition for approx. 12 h. The aqueous solution after recovery was analyzed using UV-vis spectroscopy, and the metal ion recovery capacity qr (mg/g) was calculated with the following equation:
where cr (mg/L) is the concentration of metal ions recovered from the particles, V (L) is the volume of the sample, and mP (mg) is the dry mass of the adsorbent.
For the ion extraction process, i.e., adsorption from the solution, which involves removing metal ions from a standard solution, the polymer adsorbent was mixed into 15 mL of a stock solution with a predetermined concentration of 3 × 10−2 M, for 12 h. The metal ion extraction capacity qe (mg/g) was calculated with the following formula:
where ci (mg/L) is the initial concentration of the stock solution or the contact solution, ce (mg/L) is the concentration after extraction, V (L) is the volume of the sample, and mP (g) is the dry mass of the adsorbent.
3. Results and Discussion
3.1. Synthesis of the Polymer Microspheres
To obtain polymer microsphere adsorbents with sites for metal ion adsorption, we have first synthesized the components and the intermediates: functionalized silica nanoparticles used as stabilizers of Pickering emulsions, Schiff-base ligands bearing vinyl groups, and the corresponding Schiff base–Cu(II) ion complex according to the procedures already mentioned in the experimental section. The synthesis of the bis-2-((allylimino)methyl)phenolate–Cu(II) complex was carried out at room temperature (r.t.) to avoid the formation of radicals and polymerization of the vinyl groups. See Figure 2A.
Further, for the formation of the Pickering emulsions, we have chosen a silica nanoparticle dispersion in water as the aqueous phase, a water-immiscible vinyl-bearing monomer as the organic phase (see Figure 2B) in which the metal ion complex was dissolved. A great limitation of this technique is the solubility of the Schiff base and the Schiff-base metal ion complex in the available monomers. If the ligand or the complex is insoluble in the chosen monomer, the reactions cannot be carried out. The recipes utilized in the Pickering emulsion formation and polymerization are given in Table 1. Each recipe contains a vinyl-bearing monomer that will generate the polymer matrix of the microspheres; a crosslinker, in this case EGDMA; the metal ion complex; a solvent to improve the miscibility of the components and finally the emulsion-stabilizing nanoparticles. We note that the DMSO was added to improve the solubility of the metal ion complex, and the concentration of the metal ion complex was gradually increased to the maximum solubility limit.

Table 1.
An overview of the parameters that were used to create the colloidosomes.
Next, the Pickering emulsions obtained are polymerized at 90 °C without mechanical agitation for 4 h, see Figure 2C. After reaction, the Pickering emulsion droplets are converted into polymer microspheres bearing Schiff-base metal complexes with Cu(II) ions.
The FTIR spectra of the complex and the obtained microspheres are shown in Figure 3. In the spectrum of Figure 3A, the Schiff-base complex exhibits a peak at 1612 cm−1 that can be assigned to vibrations of the imine group. This peak is present in all the spectra of the polymer microspheres, indicating that the complex was incorporated into the polymer matrix. Furthermore, the disappearance of the band at 1580 cm−1 characteristic of the vibration of the vinyl double bond is further proof of the incorporation of the complex into the polymer matrix. The participation of -OH and the imine (-C=N-) groups in the coordination of metal ions is highlighted by the presence of bands at 1325 and 1450 cm−1. The presence of the band in the 1365–1380 cm−1 region in the FTIR spectrum of samples A3, B3 and D1 can be attributed to the symmetric deformation vibration of the methyl group. After the removal of the Cu(II) ion from the A3 microspheres (Figure 3B), a shift of the peak maximum corresponding to the imine bond from 1612 cm−1 to 1636 cm−1 is observed. The absorption band corresponding to the -C-O- groups appears at 1321 cm−1 in the FTIR spectrum of A3 after the removal of the Cu(II), which, in the presence of Cu(II), is rather small. Moreover, the peak maximum corresponding to (-C-N-) bond stretching is also shifted from 1474 cm−1 to 1485 cm−1 after the removal of Cu(II).

Figure 3.
(A) FTIR spectra of the metal ion complex and the obtained microspheres (A3, B3, C3, and D1). The intensities of the spectra are normalized with respect to band of carbonyl groups. (B) FTIR spectrum of the metal ion complex, of the A3 microspheres with Cu(II) ions, and A3 microspheres after removal of Cu(II) ions.
The obtained microspheres via PEmPTech with the Schiff-base complex have been analyzed with an SEM and optical microscope, and the images are given in Figure 4 and Figure 5, respectively. The SEM images in Figure 4 present the microparticles that are partially covered by NP-Gly which were used for the stabilization of the Pickering emulsion, and which remain on the surface, partially trapped, after emulsion polymerization. In the SEM images in Figure 4, we note that the images were taken immediately after preparation and it can be observed that the NP-Gly are already falling off the surface of the microparticles due to a low contact angle with the polymer surface, i.e., low immersion depth, as extensively discussed in a previous study [33].

Figure 4.
SEM images of the microparticles immediately after synthesis (left column) and the zoomed-in area on the surface of the microspheres showing the presence of the NP-Gly that were used for the stabilization of the Pickering emulsions (right column) for (A) A3, (B) B3, (C) C3, (D) D1.

Figure 5.
Optical microscope images of microspheres: (A) A3, (B) B3, (C) C3, and (D) D1. Scale bar is 100 μm. (E) Histogram of the average size of the microparticles obtained. The error bars represent the standard error from approximately 100 measurements.
The histogram of the average size of the microparticles suggests that the average size can be controlled by the chemical composition of the emulsion droplet. The B3 microspheres have the largest average diameters and some of them exhibit deformation due to the phenomenon of “jamming”, that is, locking in the shape of a particle after deformation. This is due to the rigidity of the oil/water interface populated by nanoparticles [34]. Further, we have observed that the addition of NaVBS, a monomer surfactant, has the effect of increasing the average size diameter of the microparticles, suggesting that the emulsification power of the silica nanoparticles is deactivated. The change in the average polymer microparticle diameter of PVAc (62.1 μm), PBM (33.4 μm), and PDAEMA (31.5 μm) is the result of a complex inter-relationship between the contact angle of the silica nanoparticles at the three-phase line [33], whereas the inter-relationship between the surface tension of the water, the surface tension of the monomer, and the surface energy of the nanoparticle will determine the final contact angle of the nanoparticle at the three-phase line and its emulsification power, estimated from the curvature of the emulsion droplet radius, as we have previously shown [34]. The nature of the current observation is empirical, but the exact mechanistic description and the elucidation of the phenomenology behind the Pickering emulsion polymerization represents a long-term objective in our laboratory and a few studies have been published on this topic [23,29,33,34]. For example, we have recently shown that the larger the contact angle between the stabilizing nanoparticles and the oil phase (which translates into the low immersion of the nanoparticle into the oil phase), the larger the curvature of the obtained droplets [34]. The contact angle of the nanoparticle with the oil phase is determined largely by surface functionalization. We have chosen glycidyl functionalities because these confer nanoparticles with a very polar surface. As we have discussed previously, the type of the Pickering emulsion is mainly determined by the surface energy of the NPs and the relative polarity of the monomer and the water phase. The surface energy of the NP-Gly was previously determined (γtotal = 68 mN/m, γpolar = 42.5 mN/m, and γdisperse = 25.4 mN/m) [34]. Thus, we have demonstrated that their large polar-to-disperse surface energy components make them ideal candidates for generating o/w Pickering emulsions. However, if these nanoparticles remain the same but the polarity of the oil phase changes such that when a more polar monomer is added the immersion of the NP-Gly increases then also the curvature of the emulsion droplets must increase. At the same time, the partition of the more polar monomer between the two phases, water and oil, changes in favor of water. Therefore, the prediction of the resulting size of the polymer microspheres from a single parameter is not possible as more competing phenomena must be accounted for. Therefore, in this work, we limit our discussion only to empirical observations.
3.2. Effect of Chemical Composition on the Metal Ion Adsorption Capacity
To evidence the evolution of the metal ion adsorption capacity of the polymer microsphere adsorbents for Cu(II) metal ions, we have tested and compared the polymer microspheres obtained with the same amount of the Schiff-base metal complex copolymerized with different monomers; see Table 1. The Cu(II) ion adsorption capacity data of A3, B3, C3, and D1, for which the same concentration of 50 mg of metal ion complex was used, are given in Figure 6. From the presented data, it can be noted that the adsorption capacity for Cu(II) increases with the monomer/polymer type, in the order PBM < PVAc < PDAEMA, whereas A3 and B3 differ slightly in their composition by the addition of a slight quantity of the monomer NaVBS, which has the role of a surfactant monomer. We thus hypothesize that the adsorption capacity increases with the increase in the polar component of the surface energy of the polymer. We have previously shown that the square root of the ratio of the polar surface energy component to the dispersive energy component enables the ranking of polymers according to their polarity. The value of the polarity factor for each monomer/polymer increases in the order PBM (0.09) < PVAc (0.30) < PDAEMA (1.78). In other words, it appears that in an aqueous environment, the best-performing polymer microsphere adsorbents are those containing PDEAMA, which could be understood intuitively as the monomer/polymer that is most wetted by water; therefore, the lowest barrier to the mass transport of metal ions in and out of the polymer network. In addition, when comparing the qr values vs. qe values for the A3 and B3 microspheres that differ only in the use of a small amount of surfmer (monomer surfactant), we notice no improvement in the overall adsorption capacity of metal ions. To conclude, there is a notable increase in the adsorption capacity of the polymer microspheres when the monomer used is increasingly more polar. We therefore hypothesize that this is due to the enablement of wettability and facile mass transfer in and out of the polymer network.

Figure 6.
Recovery, extraction, and average adsorption capacity of the polymer microspheres A3, B3, C3, and D1, which have the same amount of Schiff-base metal ion complex but different polymer networks.
Thus, we clearly demonstrate that the increase in the polarity of the monomers in the polymer matrix of the microparticles does contribute towards enhancing the adsorption capacity of the microparticles towards metal ions. Thus, the ligand/complex does not need to be located on the surface of the microspheres because water does penetrate the particles to a degree controlled by the polarity of the monomers used. On the other hand, the presence of a polar nanoparticle on the surface of the microspheres may improve the initial wetting of the surface-nanostructured microspheres. It has been shown [36] that the equilibrium value of the contact angle on the nanostructured surface of the microparticles changes to a lower value with the increased polarity of the nanoparticles, due to a Cassie–Baxter to Wenzel transition state, but it is not expected to be causally connected with the adsorption capacity of the microspheres.
3.3. Effect of Ligand Concentration on the Metal Ion Adsorption Capacity
A further aspect we have tested is the influence of the Schiff-base metal ion complex concentration on the adsorption capacity of the polymer microspheres obtained. For example, for the three homologous series, A, B and C, we have prepared three members, 1, 2, and 3, as given in Table 1, whose amount of the Schiff-base metal ion complex increases progressively in the series. The data for the Cu(II) ion recovery capacity for the three series are given in Figure 7A. From the data presented, it can be noted that the recovery capacity for the Cu(II) ion increases with the Schiff-base metal ion complex used in the synthesis of the microspheres.

Figure 7.
(A) Graph showing the ion recovery capacity of the three series of polymer microsphere adsorbents with the increasing content of Schiff-base metal ion complex, for series A, B, C, and D. (B) Graph showing the Cu(II) recovery capacity with the cycle number for A3, B3, C3, and D1 samples.
Additionally, we have also tested the Cu(II) recovery capacity with the cycle number, and noticed a slight decrease in the capacity of ion adsorption for all three types of polymer microspheres, A3, B3 and C3, as shown in Figure 7B. We attribute this decrease in metal ion adsorption capacity to a partial loss of the binding ability of the microparticles. In other words, the copolymerization and inclusion of the metal ion complex with two polymerizable vinyl groups, as depicted in the Figure 2A, within the polymer network of the polymer microsphere has a crosslinking effect. During the extraction of the metal ion and protonation of imine functionality, the loss of the crosslinker may lead to a deformation of the metal ion adsorption cage or to loss of one of the ligands of the complex if it was copolymerized only at one vinyl end group. Thus, we identified two possible processes leading to a loss of the ion adsorption capacity of the polymer microspheres.
At this point, it is important to compare the performance of the polymer microspheres obtained in this work with the absorption capacity of Schiff-base ion-imprinted microbeads in the literature. In the current work, the maximum adsorption capacities for Cu(II) ions have been obtained for A3 (4.8 mg/g), B3 (5.2 mg/g), D1 (7.2 mg/g), and C3 (10.4 mg/g). Walas et al. [30] have reported polymer microsphere adsorbents obtained via suspension polymerization ion-imprinted with a salen-Cu(II) complex that have a maximum adsorption capacity of 7.04 mg/g. Apart from the work of Walas et al. reported above, we did not find any other reports for polymer microsphere adsorbents that were Schiff-base ion-imprinted for Cu(II). However, for comparative purposes, Monier and Elsayed [31] have reported the preparation of polymer microsphere adsorbents via suspension polymerization where the emulsion droplets have been imprinted for uranyl with a p-aminostyrene-salicylaldehyde Schiff base–metal ion complex with a maximum adsorption capacity for UO22+ of 147 mg/g. Unfortunately, also for other ions, examples of Schiff-base ion-imprinted microspheres are limited. On the other hand, ion-imprinted microsphere adsorbents for Cu(II) incorporating ligands or ligand ion complexes other than Schiff bases exhibit a broad range of adsorption capacities; for example, vinyl-pyridine/methacrylic acid-imprinted polymer microspheres obtained by suspension polymerization exhibit Cu(II) ion adsorption capacities in the range of 15–40 mg/g [23,37,38]. This concludes that the obtained Cu(II) ion adsorption capacities fall within the usual ranges reported in the literature.
3.4. Competitive Metal Ion Adsorption
We have also tested the performance of the polymer microsphere adsorbents in competitive adsorption experiments, namely, with a binary equimolar mixture of 1.5 × 10−2 M Cu(II) + Co(II) and Cu(II) + Ni(II) ions, and this is provided in the spectra in Figure 8. For the case of the Cu(II) + Co(II) equimolar mixture, in Figure 8A, both ions are adsorbed, such that the adsorption capacity for Co(II) is A3 (7.8 mg/g), B3 (6.4 mg/g), C3 (11.1 mg/g) and for Cu(II) is A3(1.35 mg/g), B3(1.7 mg/g) and C3 (4.6 mg/g). Both the band at 810 nm characteristic for Cu(II) and the band at 510 nm for Co(II) decrease when coming in contact with the adsorbent, which suggests that both ions compete for the same adsorption sites. On the other hand, for the binary mixture Cu(II) + Ni(II), in Figure 8B, the adsorption for Ni(II) is negligible, while for Cu(II) it follows the same trend as above, with A3 (0.85 mg/g), B3 (0.8 mg/g), and C3 (3.0 mg/g). A possible reason why the Ni(II) is not adsorbed as compared with Co(II) and Cu(II) is not only the difference in both the ionic radii, which are very similar for Co(II) and Cu(II) while for Ni(II) are much smaller, but also the different ability of the ions to form tetra-coordinated complexes as compared to the other ions [39].

Figure 8.
(A) UV-vis spectrum of the stock solution of the equimolar mixture of Cu(II) + Co(II) 1.5 × 10−2 M ions and of the mixture of ions after contact with the A3, B3, and C3 polymer microsphere adsorbents. (B) UV-vis spectrum of the stock solution of the equimolar mixture of Cu(II) + Ni(II) 1.5 × 10−2 M ions and of the mixture of ions after contact with the A3, B3, and C3 polymer microsphere adsorbents.
4. Conclusions
In this work, we have demonstrated that polymer microspheres that carry Schiff-base ligands–metal ion complexes can be produced via the Pickering emulsion polymerization technique. PEmPTech allows for a great degree of flexibility in tuning the chemical composition of polymer microspheres with the final objective of deploying them as metal ion adsorbents in aqueous solutions. Thus, the structure–activity relationship unfolds such that the increase in the polarity of the polymer matrices enhances the adsorption capacity of the microspheres. Further, the increase in the ligand concentration in the organic phase of the emulsion also leads to an increase in the adsorption capacity of the beads. The adsorption capacities obtained in this work fall in the mid-range of performance of the adsorbents reported in the literature. At the same time, the greatest limitation of PEmPTech is the solubility of the Schiff-base metal ion complex in the monomers constituting the organic phase as well as its copolymerization ability. Further work should focus on developing Schiff-base ligands with better solubility and copolymerization ability with monomers suitable for PEmPTech. We have thus demonstrated this as a feasible pathway to produce ligand-carrying polymer microspheres for potential use in water pollution mitigation.
Author Contributions
Conceptualization, A.H.; methodology, A.H., O.-I.N., A.-M.S., and M.H.; validation, A.H., O.-I.N., A.-M.S., and M.H.; formal analysis, A.H.; investigation, A.H., O.-I.N., A.-M.S., and M.H.; resources, A.H.; data curation, A.H.; writing—original draft preparation, A.H.; writing—review and editing, A.H., O.-I.N., and M.H.; visualization, A.H., O.-I.N., and M.H.; supervision, A.H.; project administration, A.H.; funding acquisition, A.H. All authors have read and agreed to the published version of the manuscript.
Funding
This work was supported by a grant of the Ministry of Research, Innovation and Digitization of Romania, CNCS/CCCDI-UEFISCDI, project number PN-III-P4-PCE-2021-0306 (Contract Nr. PCE62/2022).
Data Availability Statement
The data is available upon request.
Conflicts of Interest
The authors declare no conflicts of interest.
References
- Dean, J.G.; Bosqui, F.L.; Lanouette, K.H. Removing Heavy Metals from Waste Water. Environ. Sci. Technol. 1972, 6, 518–522. [Google Scholar] [CrossRef]
- Mansourri, G.; Madani, M. Examination of the Level of Heavy Metals in Wastewater of Bandar Abbas Wastewater Treatment Plant. Open J. Ecol. 2016, 06, 55–61. [Google Scholar] [CrossRef]
- Manzo, L. 70—Metals. In Neurobiology of Disease; Gilman, S., Ed.; Academic Press: Burlington, MA, USA, 2007; pp. 759–769. ISBN 978-0-12-088592-3. [Google Scholar]
- Rehman, K.; Fatima, F.; Waheed, I.; Akash, M.S.H. Prevalence of Exposure of Heavy Metals and Their Impact on Health Consequences. J. Cell. Biochem. 2018, 119, 157–184. [Google Scholar] [CrossRef] [PubMed]
- Kinuthia, G.K.; Ngure, V.; Beti, D.; Lugalia, R.; Wangila, A.; Kamau, L. Levels of Heavy Metals in Wastewater and Soil Samples from Open Drainage Channels in Nairobi, Kenya: Community Health Implication. Sci. Rep. 2020, 10, 8434. [Google Scholar] [CrossRef] [PubMed]
- Sharma, Y.C.; Srivastava, V.; Singh, V.K.; Kaul, S.N.; Weng, C.H. Nano-adsorbents for the Removal of Metallic Pollutants from Water and Wastewater. Environ. Technol. 2009, 30, 583–609. [Google Scholar] [CrossRef] [PubMed]
- El Ouardi, Y.; Giove, A.; Laatikainen, M.; Branger, C.; Laatikainen, K. Benefit of Ion Imprinting Technique in Solid-Phase Extraction of Heavy Metals, Special Focus on the Last Decade. J. Environ. Chem. Eng. 2021, 9, 106548. [Google Scholar] [CrossRef]
- Shakerian, F.; Kim, K.-H.; Kwon, E.; Szulejko, J.E.; Kumar, P.; Dadfarnia, S.; Haji Shabani, A.M. Advanced Polymeric Materials: Synthesis and Analytical Application of Ion Imprinted Polymers as Selective Sorbents for Solid Phase Extraction of Metal Ions. TrAC Trends Anal. Chem. 2016, 83, 55–69. [Google Scholar] [CrossRef]
- Rao, T.P.; Kala, R.; Daniel, S. Metal Ion-Imprinted Polymers—Novel Materials for Selective Recognition of Inorganics. Anal. Chim. Acta 2006, 578, 105–116. [Google Scholar] [CrossRef] [PubMed]
- Luo, F.; Huang, S.; Xiong, X.; Lai, X. Synthesis and Characterization of Hg(ii)-Ion-Imprinted Polymer and Its Application for the Determination of Mercury in Water Samples. RSC Adv. 2015, 5, 67365–67371. [Google Scholar] [CrossRef]
- Ashouri, N.; Mohammadi, A.; Shekarchi, M.; Hajiaghaee, R.; Rastegar, H. Synthesis of a New Ion-Imprinted Polymer and Its Characterization for the Selective Extraction and Determination of Nickel Ions in Aqueous Solutions. Desalination Water Treat. 2015, 56, 2135–2144. [Google Scholar] [CrossRef]
- Zhou, Z.; Kong, D.; Zhu, H.; Wang, N.; Wang, Z.; Wang, Q.; Liu, W.; Li, Q.; Zhang, W.; Ren, Z. Preparation and Adsorption Characteristics of an Ion-Imprinted Polymer for Fast Removal of Ni(II) Ions from Aqueous Solution. J. Hazard. Mater. 2018, 341, 355–364. [Google Scholar] [CrossRef] [PubMed]
- Al-Saydeh, S.A.; El-Naas, M.H.; Zaidi, S.J. Copper Removal from Industrial Wastewater: A Comprehensive Review. J. Ind. Eng. Chem. 2017, 56, 35–44. [Google Scholar] [CrossRef]
- Zhou, T.; Zhao, M.; Zhao, X.; Guo, Y.; Zhao, Y. Simultaneous Remediation and Fertility Improvement of Heavy Metals Contaminated Soil by a Novel Composite Hydrogel Synthesized from Food Waste. Chemosphere 2021, 275, 129984. [Google Scholar] [CrossRef]
- Andreazza, R.; Morales, A.; Pieniz, S.; Labidi, J. Gelatin-Based Hydrogels: Potential Biomaterials for Remediation. Polymers 2023, 15, 1026. [Google Scholar] [CrossRef]
- Britton, L.N. Surfactants and the Environment. J. Surfactants Deterg. 1998, 1, 109–117. [Google Scholar] [CrossRef]
- Ivanković, T.; Hrenović, J. Surfactants in the Environment. Arch. Ind. Hyg. Toxicol. 2010, 61, 95–110. [Google Scholar] [CrossRef] [PubMed]
- Rosen, M.J.; Li, F.; Morrall, S.W.; Versteeg, D.J. The Relationship between the Interfacial Properties of Surfactants and Their Toxicity to Aquatic Organisms. Environ. Sci. Technol. 2001, 35, 954–959. [Google Scholar] [CrossRef]
- Pérez-Moral, N.; Mayes, A.G. Comparative Study of Imprinted Polymer Particles Prepared by Different Polymerisation Methods. Anal. Chim. Acta 2004, 504, 15–21. [Google Scholar] [CrossRef]
- Daniel, S.; Prabhakara Rao, P.; Prasada Rao, T. Investigation of Different Polymerization Methods on the Analytical Performance of Palladium(II) Ion Imprinted Polymer Materials. Anal. Chim. Acta 2005, 536, 197–206. [Google Scholar] [CrossRef]
- Chaipuang, A.; Phungpanya, C.; Thongpoon, C.; Watla-iad, K.; Inkaew, P.; Machan, T.; Suwantong, O. Synthesis of Copper(II) Ion-Imprinted Polymers via Suspension Polymerization. Polym. Adv. Technol. 2018, 29, 3134–3141. [Google Scholar] [CrossRef]
- Jiang, Y.; Tang, B.; Zhao, P.; Xi, M.; Li, Y. Synthesis of Copper and Lead Ion Imprinted Polymer Submicron Spheres to Remove Cu2+ and Pb2+. J. Inorg. Organomet. Polym. Mater. 2021, 31, 4628–4636. [Google Scholar] [CrossRef]
- Honciuc, A.; Solonaru, A.-M.; Honciuc, M. Pickering Emulsion Polymerization Technology─Toward Nanostructured Materials for Applications in Metal Ion Extractions from Wastewaters. ACS Appl. Polym. Mater. 2023, 5, 8012–8022. [Google Scholar] [CrossRef]
- Croissant, J.G.; Butler, K.S.; Zink, J.I.; Brinker, C.J. Synthetic Amorphous Silica Nanoparticles: Toxicity, Biomedical and Environmental Implications. Nat. Rev. Mater. 2020, 5, 886–909. [Google Scholar] [CrossRef]
- Nworie, F.S.; Nwabue, F.I.; Elom, N.I.; Eluu, S.O. Schiff Bases and Schiff Base Metal Complexes: From Syntheses to Applications. J. Basica Appl. Res. 2016, 2, 295–305. [Google Scholar]
- Younes, A.A.; El-Maghrabi, H.H. Removal of Lead Ions from Wastewater Using Novel Schiff-Base Functionalized Solid-Phase Adsorbent. Sep. Sci. Technol. 2020, 55, 1589–1602. [Google Scholar] [CrossRef]
- Fan, H.-T.; Liu, J.-X.; Yao, H.; Zhang, Z.-G.; Yan, F.; Li, W.-X. Ionic Imprinted Silica-Supported Hybrid Sorbent with an Anchored Chelating Schiff Base for Selective Removal of Cadmium(II) Ions from Aqueous Media. Ind. Eng. Chem. Res. 2014, 53, 369–378. [Google Scholar] [CrossRef]
- Petrova, P.; Chochkova, M.; Veleva, O.; Karadjov, M. Schiff Bases Chelate Sorbents for Separation and Concentration of Pt from Sea Water and Spent Automotive Catalysts. J. Chem. Technol. Metall. 2020, 55, 691–697. [Google Scholar]
- Honciuc, A.; Negru, O.-I. Monitoring the Surface Energy Change of Nanoparticles in Functionalization Reactions with the NanoTraPPED Method. Nanomaterials 2023, 13, 1246. [Google Scholar] [CrossRef]
- Walas, S.; Tobiasz, A.; Gawin, M.; Trzewik, B.; Strojny, M.; Mrowiec, H. Application of a Metal Ion-Imprinted Polymer Based on Salen–Cu Complex to Flow Injection Preconcentration and FAAS Determination of Copper. Talanta 2008, 76, 96–101. [Google Scholar] [CrossRef]
- Monier, M.; Elsayed, N.H. Selective Extraction of Uranyl Ions Using Ion-Imprinted Chelating Microspheres. J. Colloid Interface Sci. 2014, 423, 113–122. [Google Scholar] [CrossRef]
- Monier, M.; Youssef, I.; El-Mekabaty, A. Preparation of Functionalized Ion-Imprinted Phenolic Polymer for Efficient Removal of Copper Ions. Polym. Int. 2020, 69, 31–40. [Google Scholar] [CrossRef]
- Honciuc, A.; Negru, O.-I. NanoTraPPED—A New Method for Determining the Surface Energy of Nanoparticles via Pickering Emulsion Polymerization. Nanomaterials 2021, 11, 3200. [Google Scholar] [CrossRef] [PubMed]
- Honciuc, A.; Negru, O.-I. Role of Surface Energy of Nanoparticle Stabilizers in the Synthesis of Microspheres via Pickering Emulsion Polymerization. Nanomaterials 2022, 12, 995. [Google Scholar] [CrossRef] [PubMed]
- Khorshidifard, M.; Amiri Rudbari, H.; Kazemi-Delikani, Z.; Mirkhani, V.; Azadbakht, R. Synthesis, Characterization and X-Ray Crystal Structures of Vanadium(IV), Cobalt(III), Copper(II) and Zinc(II) Complexes Derived from an Asymmetric Bidentate Schiff-Base Ligand at Ambient Temperature. J. Mol. Struct. 2015, 1081, 494–505. [Google Scholar] [CrossRef]
- Honciuc, A.; Negru, O.-I. Asymmetrically Nanostructured 2D Janus Films Obtained from Pickering Emulsions Polymerized in a Langmuir–Blodgett Trough. Micromachines 2023, 14, 1459. [Google Scholar] [CrossRef] [PubMed]
- Jiang, Y.; Kim, D. Effect of Solvent/Monomer Feed Ratio on the Structure and Adsorption Properties of Cu2+-Imprinted Microporous Polymer Particles. Chem. Eng. J. 2011, 166, 435–444. [Google Scholar] [CrossRef]
- Hoai, N.T.; Yoo, D.-K.; Kim, D. Batch and Column Separation Characteristics of Copper-Imprinted Porous Polymer Micro-Beads Synthesized by a Direct Imprinting Method. J. Hazard. Mater. 2010, 173, 462–467. [Google Scholar] [CrossRef]
- Wiberg, N.; Wiberg, E.; Holleman, A.F. Lehrbuch Der Anorganischen Chemie, 102nd ed.; Walter de Gruyter GmbH & Co.: Berlin, Germany, 2007. [Google Scholar]
Disclaimer/Publisher’s Note: The statements, opinions and data contained in all publications are solely those of the individual author(s) and contributor(s) and not of MDPI and/or the editor(s). MDPI and/or the editor(s) disclaim responsibility for any injury to people or property resulting from any ideas, methods, instructions or products referred to in the content. |
© 2024 by the authors. Licensee MDPI, Basel, Switzerland. This article is an open access article distributed under the terms and conditions of the Creative Commons Attribution (CC BY) license (https://creativecommons.org/licenses/by/4.0/).